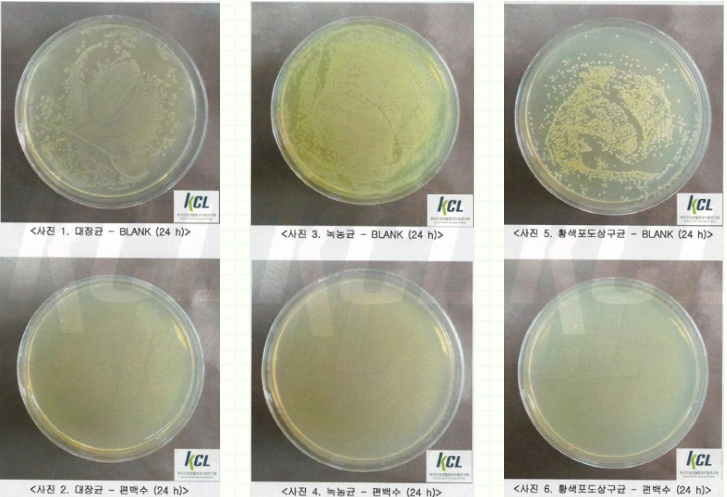
편백수 인증 결과 이미지

새 차를 구매하거나 새집으로 이사하는 경우 포름알데히드로 인해서 새 차/새집 증후군을 경험하는 분들이 많습니다. 거기에 겨울이 다가오니 창문을 열고 다니기 힘듭니다. 설상가상으로 겨울이 되면 호흡기 질환도 자주 발생합니다. 그래서, 본격적으로 추워지기 전에 가족 건강을 개선할 수 편백수의 효과와 효능 및 사용법에 대해서 알아보겠습니다.

Table Of Contents
새집증후군과 겨울철 호흡기 질환(감기)
아마도 차량을 구매하시거나 새집으로 이사하신 분들은 새차증후군 혹은 새집증후군을 겪으실 수밖에 없을 거라 생각합니다. 저도 새 차를 구매해 보기 전에는 몰랐는데 정말 생각보다 심했습니다. 이사 왔을 때도 한동안 눈에서 눈물이 사라지지 않을 정도로 심한 새집증후군을 겪기도 하였습니다.
차량을 구매한 후, 새차 특유의 냄새가 예상보다 강하게 느껴졌습니다. 방향제를 사용하여 해결하려 했으나, 새 차 냄새와 방향제가 섞여 더 이상한 냄새가 발생하여 방향제는 치워버렸습니다.

저희는 종종 아이들과 함께 차를 타고 다니는데, 새차 증후군으로부터 아이들이 안 좋은 영향을 받을까 걱정되었습니다.
냄새가 강할 때는 창문을 주로 열어 환기를 시도했지만, 날씨가 점차 쌀쌀해지면서 창문을 열고 다니기가 어려워지고 있습니다. 그래서, 다른 해결책을 찾아야겠다고 생각하였습니다.
새 차증후군에 편백수가 좋다고 하여 차를 처음 사고 편백수 원액을 구매를 했었는데, 구매하고 나서 사용해 보니 이상한 냄새가 섞여서 나서 성분을 자세히 보니 편백수 외에 다른 인공 첨가물이 있었습니다. 그래서 그 인공적인 향 때문에 사용을 못한 적이 있습니다.

겨울철 감기
겨울이 되면 날씨도 추워지고 건조해져서 호흡기 질환을 주의해야 합니다.
날씨가 쌀쌀해지고 겨울이 되니 건조해서 자고 일어나면 목이 아프기 시작합니다. 아이들도 하나둘씩 기침을 하는 소리도 들리니 신경이 쓰입니다.
지금은 보일러나 난방을 많이 하지 않는데, 보일러를 틀거나 난방을 하게 되면 더 건조해 지므로 가습기를 꼭 사용해야 합니다.
제가 워낙 웰빙이나 건강에 관심이 많고 피톤치드나 천연 성분등에 관심이 많아서 예전에는 아이들 방에 천연 피톤치드 발생기를 두었었는데, 피톤치드 발생기를 제조하는 회사가 사라지면서 더 이상 해당 제품에 사용하는 피톤치드 리필제품을 구매하지 못하게 되었습니다.
천연 피톤치드 향이 집안에 날 때는 기분도 상쾌하고 좋았었는데, 아쉬움이 컸습니다.
또한, 가습기에 섞어서 사용하면 면역력을 높여주어 겨울철 아이들의 감기 예방 및 성인에게도 좋습니다.
편백수는 다음과 같이 작용하여 포름알데히드를 제거하고 건강을 지켜주는 역할을 합니다.
- 편백수는 편백나무에서 추출한 물로, 천연 항균 물질인 피톤치드를 풍부하게 함유하고 있습니다. 피톤치드는 공기 중의 포름알데히드와 화학적으로 반응하여 분해하고 흡착합니다. 이를 통해, 포름알데히드를 효과적으로 제거합니다.
- 편백수를 가습기에 넣어 분사하면, 공기 중의 수증기와 포름알데히드가 결합하여 메탄산이라는 무해한 물질로 변합니다. 이렇게 변한 메탄산은 쉽게 수증기로 증발하거나 흡수됩니다.
- 편백수를 가습기에 넣어 분사하면, 공기 중의 음이온이 증가합니다. 음이온은 공기 중의 유해물질을 중화하거나 응집시켜 제거하는 역할을 합니다. 음이온은 또한 포름알데히드와 같은 유기 오염물질을 산화시켜 이산화탄소와 물로 분해합니다.
- 편백수는 대장균, 녹농균, 황색포도상구균 등을 제거하는 효과가 있습니다. 가습기에는 이러한 균들이 서식하기 쉬운데, 이를 제거하여 가습기를 건강하게 사용할 수 있도록 도와줍니다.

편백수 원액 구매 시 고려사항
1. 순수한 100% 원액인지 확인
편백수 원액을 구매하실 때에는 다른 성분의 첨가가 없는 순수한 100% 편백수 원액을 구매해야 합니다. 추가로 소모품 제품들은 한번 쓰고 나면 반품이나 교환을 할 수가 없으니 확실히 확인해 보고 구매하시는 것을 추천드립니다.
2. 인증받은 제품인지 확인
대장균, 녹농균, 황색포도상구균등에 대해 "KCL 한국건설생활환경시험연구원"에서 인증시험을 거쳤는지 확인해 보시는 것이 중요합니다. 이것은, 실제로 제품이 항균력을 가졌는지를 볼 수 있습니다.
그리고, 이런 시험을 거치지 않은 제품들은 실제 항균 효과가 없는 정도에서 그치는 것이 아니라 오히려 몸에 해로운 균들이 배양될 수 있으므로 세균 배양 실험을 통해서 항균력이 있는지를 시험하고 인증받은 것을 확인해 보시는 것이 중요합니다.
3. 대용량으로 구매
편백수는 생각보다 많이 사용하게 됩니다. 저의 경우 가습기에 섞어서 사용하는데, 많게는 1:1에서 적게는 20:1까지도 넣어서 사용하실 수 있습니다. 물론 많이 사용하실수록 피톤치드가 더 많이 섞여 나와서 좋습니다.
100% 순수한 피톤치드 원액의 경우에는 원액만 직접 가습기에 넣어서 사용해도 되는 제품이지만 현실적으로 비용 때문에 그렇게 하지는 못합니다.
편백수 원액은 나뿐 아니라 우리 가족의 건강을 지키는데 큰 역할을 하는 제품입니다. 겨울만 되면 목도 아프고 감기와 같은 호흡기 질환에 잘 걸리시는 분들은 꼭 사용해 보시기를 추천드립니다. 가족들이 한 명 감기 걸리면 다 같이 걸리곤 하는데 이번 겨울에는 건강하게 지낼 수 있을 것 같습니다.
100% 순수한 피톤치드 편백수 원액 + KCL 인증 + 대용량의 저렴한 가격을 가진 제품 중 저렴한 제품으로 찾아보았습니다.
KCL 인증된 100% 편백수 2L 정도의 대용량 중 가장 저렴하게 판매하는 링크를 아래에 걸어 두었으니 참고해 보시기 바랍니다. (현재 30% 할인 판매 중입니다.)
▼▼▼
편백수 원액을 가습기에 사용하시려면 자주 사용하게 되는 제품이라 많이 구매해 두고 쓰시는 것이 좋습니다. 사실 제가 가습기 사용법과 새집증후군 사용법을 분리하기는 했지만, 새집증후군이 있으신 분들은 가습기 사용은 필수라고 생각하시는 것이 좋습니다.
가습기에 사용하시면 지속적으로 새집증후군에서 발생하는 포름알데히드를 제거하는 효과가 있어서 새집증후군으로 고생하시는 분들은 짙은 농도(물 3:편백수 1 정도)로 가습기에 섞어서 사용해 주시는 것이 좋습니다.
가습기 사용법
평소에 가습기에 섞어서 사용하실 때에는 5:1 정도로 넣으면 아침에 방안에 피톤치드 향이 풍부하게 나는 게 아주 좋습니다.
하지만, 사용감이 너무 많아서 저의 경우 아끼느라.. 20:1 정도로 사용합니다. 즉, 물 1L에 50ml 정도 섞어서 사용합니다. 이 정도만 섞어서 사용하더라도 항균효과를 기대할 수 있고 아침에 일어나면 상쾌한 것을 느끼실 수 있습니다. 사실 저는 5:1로 사용하고 싶어요.. ^^
저의 경우에는 자기 전에 가습기에 섞어서 사용합니다. 겨울철에 감기를 예방하고 목을 보호하는 데는 가습기가 좋은데 가습기의 단점이 세균들이 잘 번식한다는 것입니다.
그런데, 여기에 균 제거 효과가 입증된 편백수 원액을 섞어 쓰면 세균 억제 및 제거 효과가 있으니 안심하고 가습기를 사용하실 수 있습니다. 뿐만 아니라 그 편백수가 섞인 가습을 통해서 공기를 정화시켜 주는 역할도 하며, 최종적으로 피톤치드를 흡수할 수 있어서 호흡기 질환을 예방하는 데에도 도움이 됩니다.
그러므로, 가습기 관리에도 도움이 되며 겨울철 건강 관리에 도움이 되는 편백수를 가습기에 넣는 것은 매우 좋습니다.
새집증후군과 새차증후군을 제거하는 사용법
새집증후군
새집증후군을 제거하기 위해서 사용하실 때에는 연무기와 같은 제품을 함께 사용하시는 것을 추천드립니다.
하지만, 연무기가 없다면 일반 스프레이로 뿌려주셔도 됩니다. 다만, 스프레이로 뿌리시면 손이 아프실 수는 있습니다. 요즘에는 가정에서 사용하실 수 있는 저렴한 가격의 연무기가 많이 나오니 새집증후군 제거를 위해서라면 하나쯤 구매하시는 것을 추천드립니다.
편백수 분무는 주로 벽지나 가구 등 유해물질이 나오는 곳에는 모두 뿌려주시면 됩니다.
또한, 주무시기 전에 커튼이나 침구에 한 번씩 뿌려주시면 상쾌하게 주무실 수 있습니다.
앞서 설명드린 것처럼 가습기도 함께 사용하시면 더 빠르게 포름알데히드를 제거하고 새집증후군에서 해방될 수 있습니다.
새차증후군
차량에 사용하는 것은 차를 탈 때마다 스프레이나 연무기를 가져가서 자동차 여기저기 특히 패브릭(천)으로 되어있는 차량 천장과 가죽으로 되어있는 시트에 많이 뿌려 줍니다. 플라스틱으로 만들어진 곳은 많이 뿌리면 흘러내려서 살짝 뿌리고 닦아주거나 귀찮을 때는 그냥 조금씩만 뿌려줍니다.
차를 타기 전에 이렇게 한 번씩 뿌려주고 타면 피톤치드 냄새가 탈취제 역할을 하기도 하고 포름알데히드 제거 효과로 인해 머리가 아픈 것이 줄어듭니다.
결론
오늘은 새집증후군과 새 차증후군을 제거하고 겨울철 호흡기질환을 예방할 수 있는 편백수에 대해서 알아보았습니다.
이 글의 설명을 통해서 편백수가 어떻게 새집증후군과 새차증후군을 제거하고 호흡기 질환을 예방하는지 이해하셨을 것이라 생각합니다.
편백수를 고를 때에는 100% 순수 원액, 인증, 대용량의 세 가지를 고려해서 구매해야 한다는 것도 알아보았습니다.
마지막으로 새집증후군과 새차증후군을 제거하기 위한 편백수 사용방법도 알아보았고, 추가로, 겨울철 감기예방을 위해서 가습기 사용과 편백수를 이용해서 가습기를 편리하게 관리하고 감기예방에 도움이 되는 방법을 알아보았습니다.
오늘 내용이 도움이 되셨기를 바라며, 가족의 건강을 위해서 편백수를 이용해 보시는 것을 추천드립니다.
감사합니다.
참고자료
논문:
- Comparing the efficiency of formaldehyde removal methods and exploring chemical principles and most efficient methods of elimination
특허:
- 피톤치드를 발산하는 조립형 나무필터 가습기 및 조립형 나무필터 공기정화장치
- 편백나무 잎을 이용한 가습액 제조방법 및 그에 의해 제조된 가습액
- 편백정유를 유효성분으로 함유하는 호흡기 염증 질환의 예방, 개선 또는 치료용 조성물
기타:
- KCL 한국건설생활환경시험연구원






